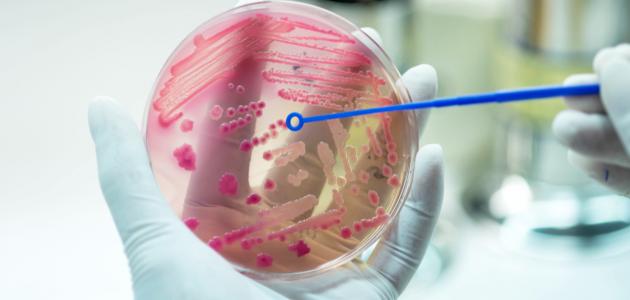
التهاب بالدم عند الأطفال التهاب بالدم عند الأطفال

محتويات
يحدث التهاب الدم أو ما يُعرف بالإنتان (بالإنجليزية: Sepsis) كردّة فعل من الجسم على الإصابة بالعدوى، كالتهاب المسالك البولية، أو الالتهاب الرئوي (بالإنجليزية: Pneumonia)، أو التهاب الجلد، أو التهاب العظام، أو التهاب السحايا (بالإنجليزية: Meningitis)، وإذا لم يُعالج في الوقت المُناسب، فإنّه قد يؤدي إلى تلف الأنسجة، وفشل الأعضاء، ثمّ موت الطفل، وعلى الرّغم من أنّه قد يُصيب أيّ عمر، إلّا أنّه أكثر شيوعاً بين كبار السنّ والأطفال، خاصّةً الأطفال حديثي الولادة والرُّضع، وتجدر الإشارة إلى أنّ التهاب الدم الذي يُصيب الرُّضع خلال 90 يوماً من ولادتهم يُعرف بإنتان الرُّضع (بالإنجليزية: Neonatal sepsis).[١]
تشمل أعراض التهاب الدم لدى الأطفال الأعراض الشائعة للإصابة بالعدوى؛ كالحُمّى، أو السّعال، أو الإسهال، بالإضافة إلى الأعراض التالية:[٢]
- تسارع نبضات القلب.
- زيادة سرعة التّنفس.
- انخفاض ضغط الدم.
- برودة الجلد.
- الشعور بنعاسٍ مُفرطٍ.
- الشعور بالارتباك.
يبدأ تشخيص التهاب الدم بقياس بدرجة حرارة الجسم، وسرعة دقات القلب، وسرعة التّنفس، وقد يطلب الطبيب فحص الدم، بالإضافة إلى الفحوصات التالية:[٣]
- فحص البول أو البراز.
- أخذ عيّنةٍ من أنسجة، أو جلد، أو سوائل المنطقة المُصابة لفحصها.
- أخذ عيّنةٍ من اللعاب، أو البلغم، أو المُخاط لفحصها
- فحوصات ضغط الدم.
- التصوير بالأشعة؛ كالتصوير بالأشعة السينيّة، والتصوير بالموجات فوق الصّوتية، أو التصوير المقطعي المُحوسب (بالإنجليزية: CT scan).
يُعالج التهاب الدم في المستشفى؛ حتى يتمكّن الأطباء من مراقبة ومتابعة المريض عن كثب، وفي بعض الأحيان قد يحتاج الطفل لدخول وحدة العناية المُركّزة للأطفال (بالإنجليزية: Pediatric intensive care unit)؛ لمراقبة حالته الصّحيّة بشكلٍ أفضل، وتشمل الخيارات العلاجيّة ما يأتي:[٤]
- المُضادّات الحيوية: تُعطى بالوريد للقضاء على العدوى.
- السوائل وأدوية ضغط الدم: قد يُعطى المريض سوائل عن طريق الوريد، بالإضافة إلى أدوية أخرى تُحافظ على عمل القلب بكفاءة.
- إجراءات أخرى: في بعض الأحيان قد يحتاج المريض إلى نقل دمٍ، أو تزويده بالأكسجين إذا كان يُعاني من صعوبةٍ في التّنفس، وفي حال حدوث تلفٍ في الكلى وتوقفها عن إنتاج البول، فإنّ الطبيب قد يلجأ إلى الغسيل الكلوي (بالإنجليزية: Dialysis)؛ لتنقية الدم.
- ↑ Sylvia Owusu-Ansah (9-11-2017), “Sepsis in Infants & Children”، www.healthychildren.org, Retrieved 11-5-2019. Edited.
- ↑ “Sepsis”, www.aboutkidshealth.ca,19-7-2017، Retrieved 11-5-2019. Edited.
- ↑ “Sepsis”, www.nhs.uk,7-6-2017، Retrieved 11-5-2019. Edited.
- ↑ Hannah R. Stinson (1-8-2018), “Sepsis”، kidshealth.org, Retrieved 11-5-2019. Edited.









